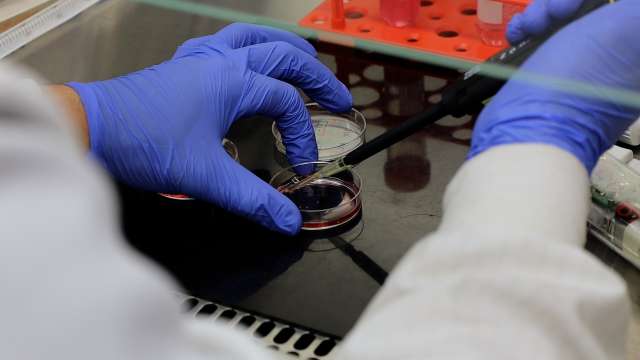
Researcher using pipette and petri dish

Residency
Welcome to the UCLA Adult Neurology Residency Program
UCLA Neurology offers a nationally recognized residency program that combines broad clinical training with mentorship from leading experts across all neurological subspecialties. Guided by curiosity, compassion, and a commitment to excellence, our residents care for a large and diverse patient population across multiple facilities, including Ronald Reagan UCLA Medical Center—one of the nation’s top tertiary referral centers. Consistently ranked among the top 10 neurology residency programs by Doximity, we are proud to train future neurologists through unparalleled clinical experience in one of the most dynamic and diverse regions in the country.
Neurology Residency Program | Why Choose UCLA Health?

Education Through Experience
Residents are given a broad range of clinical experience by virtue of the large and diverse population of patients served, the multiple facilities through which residents rotate, and the broad scope of faculty expertise. Our residents gain their clinical training through a combination of inpatient and outpatient rotations, conferences, formal didactics, and peer-to-peer teaching.
Customize Your Training
Our program offers a uniquely broad and rich clinical education, supported by diverse training sites and a wide range of faculty expertise. This strong foundation allows residents to customize their experience through optional specialized tracks: Research Development, Clinical Educator, Inclusive Excellence, and Global Health. These tracks empower residents to shape their own career path and explore their professional interests.

Live Well, Train Well
Life as a UCLA Neurology resident is defined by both professional excellence and a strong sense of community. Our residents form lasting bonds through shared dedication, support for one another, and a genuine love for neurology. We foster connection and well-being through department-led wellness initiatives, social events, and a culture that prioritizes balance alongside rigorous training.
A Balanced Schedule

Follow us on social media
Meet the Chief Residents

Congratulations to Drs. Sebastian Green, Elaine Ramirez, and Edith Yuan for their appointments as the 2025-2026 UCLA Neurology Chief Residents! We are looking forward to seeing their leadership, care, and excellence in action. Read about their motivations to pursue neurology, aspirations for this upcoming year, and more!